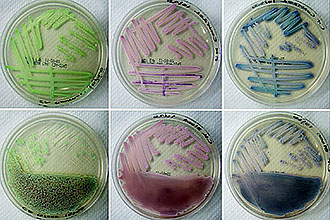
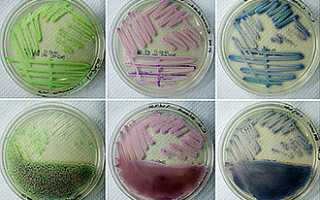

Этиология
В холодный сезон, особенно в межсезонье, иммунная система человека ослабевает, что создает условия для активности патогенных микроорганизмов.
Основными возбудителями фолликулярного тонзиллита являются:
- бета-гемолитический стрептококк группы А,
- стафилококки,
- адено- и риновирусы,
- грибки рода Candida.
Гнойная фолликулярная ангина в 70% случаев вызвана стрептококком, находящимся в ротовой полости. Для быстрого развития инфекции необходимо снижение иммунной защиты, что чаще всего происходит по следующим причинам:
- переохлаждение;
- нехватка витаминов и анемия;
- наличие хронических заболеваний;
- недостаток сна и постоянные стрессы;
- несбалансированное питание;
- вторичный иммунодефицит.
| ФОЛЛИКУЛЯРНАЯ АНГИНА. ЭТИОЛОГИЯ | ||
| Причины возникновения | Пути передачи возбудителя | Способы заражения |
| патогенные микроорганизмы (стрептококки и стафилококки); ослабление иммунной системы. | эндогенный (возбудитель находится в организме без симптомов и при снижении иммунитета вызывает заболевание); экзогенный (патоген проникает извне). | воздушно-капельный; контактно-бытовой; фекально-оральный (через пищу или воду). |
Снижение иммунной защиты в ротовой полости приводит к образованию гнойных очагов в фолликулах (скоплениях лимфоузлов) миндалин. Развитие интоксикации сопровождается характерными симптомами: головные боли, ломота в теле и тошнота.
Фолликулярная ангина, по мнению врачей, представляет собой острое инфекционное заболевание, характеризующееся воспалением небных миндалин. Врачи отмечают, что это заболевание чаще всего вызывается бактериальной инфекцией, особенно стрептококками. Симптомы включают сильную боль в горле, затрудненное глотание, повышение температуры и общее недомогание. Врачам важно подчеркнуть, что фолликулярная ангина требует своевременной диагностики и лечения, так как без адекватной терапии могут возникнуть серьезные осложнения, такие как абсцесс или ревматизм. Лечение обычно включает антибиотики и симптоматическую терапию для облегчения состояния пациента. Врачи рекомендуют не заниматься самолечением и обращаться за медицинской помощью при первых признаках заболевания.

Симптомы
В патогенезе фолликулярной ангины симптомы проходят через несколько этапов. Многие из них схожи с проявлениями гриппа, ОРВИ, других форм ангины, мононуклеоза и кандидоза ротовой полости. Неправильное лечение или его отсутствие могут привести к тому, что стрептококк проникает в кровь, вызывая интоксикацию организма.
Одним из характерных признаков является поражение лимфоидной ткани миндалин, которые менее защищены от воздействия внешней среды по сравнению с подкожными лимфатическими узлами. При дыхании гланды контактируют с микробами.
При адекватном лечении продолжительность болезни обычно не превышает 10 дней.
Своевременное обращение к врачу поможет избежать осложнений, которые могут возникнуть при ангине, среди которых:
- паратонзиллярный абсцесс;
- острый гнойный лимфаденит;
- ревматизм;
- инфекционный полиартрит;
- миокардит.
Фолликулярная ангина особенно опасна во время беременности из-за возможных осложнений. Развитие гнойных процессов может привести к менингиту, острому отиту и сепсису, так как иммунитет женщин в этот период ослаблен. Острый тонзиллит представляет угрозу как для здоровья женщины, так и для будущего ребенка.
Инкубационный период (время от заражения до появления первых симптомов) составляет от 10 часов до 2 суток. Микробы начинают накапливаться в лимфатической ткани миндалин. Размножение возбудителей приводит к воспалению поверхностных тканей, которое может затрагивать более глубокие слои. Без своевременного лечения катаральный тонзиллит часто переходит в фолликулярный, который проявляется следующими симптомами:
- высокая температура (39–40 градусов), плохо поддающаяся жаропонижающим средствам;
- головная боль;
- ломота в мышцах и суставах;
- дискомфорт при глотании, усиливающаяся боль в горле, отдающая в ухо;
- наличие желтых и белых гнойников на миндалинах;
- увеличение региональных лимфатических узлов, болезненность при пальпации;
- боль при повороте головы.
| Симптом | Описание | Возможные осложнения |
|---|---|---|
| Высокая температура (38-40°C и выше) | Сильное повышение температуры тела, часто сопровождается ознобом. | Ревматизм, гломерулонефрит, сепсис |
| Боль в горле | Интенсивная боль при глотании, может отдавать в уши. | Абсцесс, флегмона |
| Отек миндалин | Миндалины увеличены в размере, ярко-красного цвета, покрыты фолликулами (белыми или желтоватыми гнойными точками). | Обструктивная апноэ сна |
| Налет на миндалинах | Характерный белый или желтоватый налет, состоящий из гнойных фолликулов, не снимается легко. | Хронический тонзиллит |
| Головная боль | Может быть сильной и постоянной. | Менингит (в редких случаях) |
| Слабость, недомогание | Общее чувство слабости, утомляемости, снижение работоспособности. | Иммунодефицитные состояния |
| Боль в мышцах и суставах | Может сопровождаться миалгией и артралгией. | Ревматическая лихорадка |
Особенности течения болезни у детей
Гнойная ангина у детей встречается значительно чаще, чем у взрослых, из-за особенностей строения лимфоидной ткани. У маленьких пациентов это заболевание обычно протекает тяжелее.
В большинстве случаев наблюдается высокая температура, достигающая 40 градусов, а также лихорадка и интенсивные головные боли. К привычным симптомам могут добавляться:
- тошнота и рвота;
- головокружение;
- менингиальные симптомы (ригидность шейных мышц);
- потеря сознания.
У абсолютно здоровых детей могут наблюдаться гипертрофированные миндалины. В то же время воспалительный процесс может развиваться и при нормальном размере миндалин.
Фолликулярная ангина — это острое инфекционное заболевание, которое поражает миндалины и сопровождается выраженными симптомами. Люди часто описывают её как одну из самых болезненных форм ангины. Основные признаки включают сильную боль в горле, затруднённое глотание, высокую температуру и общее недомогание. Многие отмечают, что при фолликулярной ангине на миндалинах появляются гнойные пробки, что делает заболевание легко узнаваемым. Важно, что при первых симптомах стоит обратиться к врачу, так как неправильное лечение может привести к осложнениям. Некоторые пациенты делятся опытом, что приём антибиотиков и соблюдение постельного режима значительно ускоряют выздоровление. Кроме того, многие рекомендуют полоскания и обильное питьё для облегчения состояния.

Постановка диагноза
В большинстве случаев для постановки диагноза достаточно сбора анамнеза болезни. Для более точного определения формы заболевания проводят осмотр ротовой полости и глотки пациента, а также фарингоскопию. В этом процессе можно наблюдать характерные признаки воспаленных миндалин: значительное увеличение, отечность, яркая гиперемия (покраснение), а поверхность миндалин покрыта бело-желтыми бугорками. Мягкое небо также отекает и краснеет. После созревания фолликулы вскрываются, образуя пленки бело-желтого цвета, которые легко снимаются шпателем без следов кровотечения, что отличает это состояние от дифтерии.
Дополнительно для исследования применяются общий анализ крови, который показывает резкое увеличение СОЭ, лейкоцитов и эозинофилию, а также рост количества палочкоядерных и сегментоядерных лейкоцитов. Проводятся бактериологические исследования мазков с миндалин и анализ крови для выявления возбудителя.
Фолликулярная ангина без температуры
Гипертермия часто наблюдается при гнойниках на миндалинах. Этот симптом указывает на активную борьбу организма с инфекцией.
Однако в последние годы эксперты фиксируют случаи, когда заболевание протекает без повышения температуры. Важным аспектом для установления диагноза остается осмотр горла. Нормальная температура тела при гнойном воспалительном процессе может свидетельствовать о:
- ослаблении иммунной системы и истощении организма;
- наличии аутоиммунного заболевания;
- переходе болезни в хроническую форму;
- алкогольной интоксикации;
- сердечной недостаточности;
- менструальном цикле.
Общие принципы терапии
Эффективное лечение медикаментами невозможно без строгого соблюдения следующих рекомендаций:
- Соблюдайте постельный режим и избегайте прогулок на свежем воздухе в течение 5-6 дней, чтобы предотвратить резкое ухудшение состояния.
- Употребляйте много теплых напитков, особенно негазированной минеральной воды, молока с содой и травяных настоев с добавлением шиповника, ромашки и шалфея. Температура жидкости должна быть умеренной, чтобы не повредить воспаленную слизистую.
-
Питание должно состоять из однородной пищи без острых приправ, включая каши, бульоны, пюре и супы.
Твердая пища может усиливать дискомфорт при глотании и привести к механическим повреждениям воспаленных участков ротовой полости и глотки.
-
Помещение, где находится пациент, должно ежедневно очищаться и проветриваться.
- Регулярное полоскание горла 7-10 раз в день поможет удалить гнойные выделения, образующиеся после созревания и вскрытия фолликула.
Пациент может начать чувствовать себя лучше уже через 5 дней, однако не стоит сразу возвращаться к работе и посещать общественные места. Иммунной системе требуется время для восстановления после болезни. Врачи советуют в течение 10 дней ограничить контакты с внешней средой. Для улучшения состояния здоровья важны здоровый сон, полноценный отдых и сбалансированное питание, включая овощи и фрукты.
Антибактериальная терапия
Фолликулярный тонзиллит может привести к серьезным осложнениям, самым опасным из которых является ревматизм. Это заболевание вызывает тяжелые пороки сердечных клапанов и может привести к инвалидности. Основным методом лечения бактериальной инфекции являются антибиотики.
Если у пациента нет аллергии, врач может назначить антибиотики из двух основных групп:
- Пенициллины — обладают широким спектром действия и эффективно борются со стрептококками и стафилококками. Наиболее известный представитель этой группы — Амоксицилин. Курс лечения обычно составляет 10 дней. Если возбудитель проявляет устойчивость, может быть назначен Аугментин (комбинация амоксициллина с клавулановой кислотой).
- Макролиды — накапливаются в организме постепенно. К ним относятся Азитромицин (Сумамед), джозамицин и кларитромицин. Курс приема этих препаратов обычно длится до 5 дней, что позволяет эффективно воздействовать на бактерии в течение 10 дней.
Эффективность назначенного антибиотика врач оценивает через 72 часа. Показателями успешного лечения являются снижение температуры и улучшение общего состояния пациента. Если препарат не дает ожидаемого результата, его заменяют на антибиотик из другой группы.
При проведении антибактериальной терапии крайне важно строго следовать режиму и срокам приема назначенного лекарства. Преждевременное прекращение курса антибиотиков может привести к развитию устойчивости бактерий к препарату, что сделает его неэффективным в случае рецидива или осложнений.
Хирургическое лечение
При частом возникновении тонзиллита врач может рекомендовать тонзилэктомию, то есть удаление миндалин. Основные показания для этой операции:
- отсутствие эффекта от антибиотикотерапии;
- увеличение миндалин, затрудняющее глотание и дыхание;
- распространение гнойного воспаления на соседние ткани.
Для удаления миндалин используют различные инструменты: инфракрасные, электрические и ультразвуковые скальпели, а также углеродный лазер для их уменьшения.
Средства альтернативной медицины
Некоторые народные рецепты могут дополнить основное лечение и ускорить выздоровление. Для приготовления антибактериального раствора для полоскания горла вам понадобятся:
- 1 свекла,
- 1 столовая ложка 6% яблочного уксуса.
Свеклу натрите на мелкой терке и смешайте с уксусом. Дайте смеси настояться в темном месте в течение 4 часов, затем процедите сок через плотную ткань. Получившимся раствором рекомендуется полоскать горло каждые 3 часа.
Мед и продукты пчеловодства также помогают снизить воспалительные процессы. Небольшой кусочек прополиса, который нужно жевать после еды три раза в день в течение 2-3 дней, может облегчить симптомы фолликулярной ангины. Качественный прополис вызывает ощущение покалывания или жжения во рту.
Ягоды и спелые фрукты способствуют восстановлению ослабленного иммунитета. В холодное время года их можно заменить малиновым вареньем или клюквенным морсом. Добавляйте ежевику, малину и шиповник в различные травяные чаи, например, с цветками липы или чабреца.
Важно помнить, что народные рецепты не заменяют медикаментозное лечение, и перед их применением необходимо проконсультироваться с врачом.

Источники: medscape.com, health.harvard.edu, medicalnewstoday.com.
Вопрос-ответ
Чем опасна фолликулярная ангина?
Если не обратиться к врачу и не начать лечение фолликулярной ангины своевременно, могут возникнуть осложнения. К ним относятся паратонзиллярный и заглоточный абсцесс, поражение оболочек сердца (перикарда, миокарда), воспаление околоносовых пазух.
Как выглядит горло при фолликулярной ангине?
Изменения миндалин. Основной признак фолликулярной ангины – нагноение фолликулов небных миндалин. Воспаляясь, они отекают, увеличиваются в объеме и становятся красными. На их поверхности появляются небольшие, величиной до 3-4 мм, беловато-желтые островки — это и есть нагноившиеся фолликулы.
Нужно ли пить антибиотики при фолликулярной ангине?
Да, при фолликулярной ангине, которая чаще всего вызывается бактериальной инфекцией, рекомендуется принимать антибиотики для эффективного лечения и предотвращения осложнений. Однако назначение антибиотиков должно осуществляться врачом на основе клинической оценки и результатов анализов.
Советы
СОВЕТ №1
При первых симптомах фолликулярной ангины, таких как сильная боль в горле и высокая температура, не откладывайте визит к врачу. Чем раньше начнется лечение, тем быстрее вы сможете восстановиться и избежать осложнений.
СОВЕТ №2
Обратите внимание на свое питание. Употребляйте мягкую и питательную пищу, такую как супы и пюре, чтобы не раздражать горло. Также важно пить много жидкости, чтобы избежать обезвоживания и помочь организму бороться с инфекцией.
СОВЕТ №3
Следите за гигиеной. Часто мойте руки и используйте индивидуальные предметы личной гигиены, чтобы предотвратить распространение инфекции на других членов семьи.
СОВЕТ №4
Не забывайте о важности отдыха. Дайте своему организму время на восстановление, избегайте физических нагрузок и стрессов, чтобы ускорить процесс выздоровления.